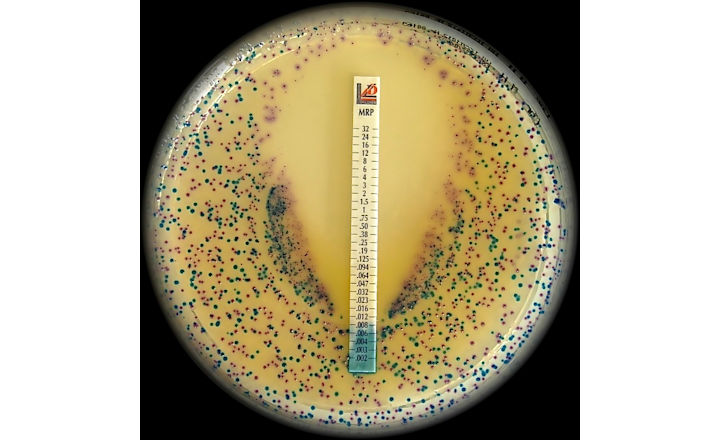

One of the current most serious global threats to human health is the increase and spread of antimicrobial-resistant organisms.
Liofilchem contributes to the fight against these organisms by providing a wide range of solutions for antibiotic susceptibility testing (AST) and antimicrobial resistance mechanisms detection:
The Liofilchem MTS™ (MIC Test Strip) is a quantitative assay for determining the Minimum Inhibitory Concentration (MIC) of antimicrobial agents against microorganisms, to indicate appropriate patient treatment and for identifying resistance patterns such as ESBL, KPC, AmpC, MBL, GRD.
MTS™ are made of special* porous matrix (*European patent granted) impregnated with a predefined concentration gradient of antibiotic, across 15 two-fold dilutions like those of a conventional MIC method.
MTS™ are available in a large variety of antibiotic configurations (over 150 agents), each configuration is available in packs of 10 strips, 30 strips and 100 strips. MTS™ can be conveniently crossed with the MTS™ Synergy Application System (Patent granted in Europe, USA and Canada) for a critical assay such as the in-vitro combination of antibiotics.
Antibiotic discs, Antimycotic discs, Multodiscs and Disc kits for resistance mechanisms detection including combinations in accordance with EUCAST and CLSI.
Ready-to-use Agar Dilution panels (Patent pending in Europe, USA and Canada): The new AD Fosfomycin 0.25-256 is the first and only (international patent pending) ready-to-use commercially available kit for performing the agar dilution antimicrobial susceptibility testing, in compliance with the CLSI and EUCAST standards, with 4 months shelf life at present.
The AD Fosfomycin panel comprises 12 wells, containing the antibiotic incorporated into an agar medium in different concentrations, i.e. 11 two-fold dilutions (0.25-256 µg/mL). The ready-to-use Agar Dilution panels by Liofilchem can be requested in custom assortments of antibiotics and concentrations.
ComASP® (Compact Antimicrobial Susceptibility Panel) for determining MIC through broth microdilution according to ISO 20776-1:2019 standard. 32-well panel Liofilchem developed its broth microdilution range on a proprietary compact format.
ComASP® is available as presets of agents such as Colistin, Oritavancin, antifungals, etc. and can also be requested in custom assortments of antibiotics and concentrations to meet the special needs of laboratories of any sizes carrying out antimicrobial susceptibility tests.
Rapid ESBL NP® test and RapidResa Polymyxin Acinetobacter NP® test have been developed by Liofilchem in collaboration with Prof. Patrice Nordmann, University of Fribourg, Switzerland, for the rapid detection of antimicrobial resistance mechanisms.
Chromogenic culture media for detecting antimicrobial resistance mechanisms, such as Chromatic Colistin, ESBL, CRE, OXA-48, VRE, MRSA series and Chromatic MH for the simultaneous identification and susceptibility testing of various microorganisms from clinical specimens, including the direct testing from CSF and positive blood culture.